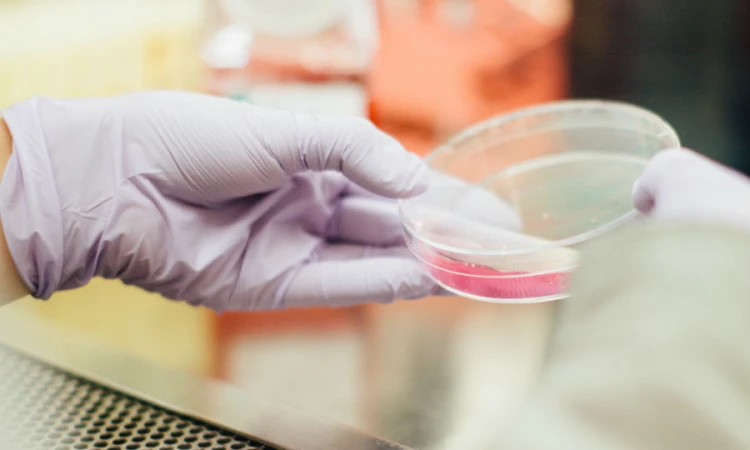

Apr 2, 2017
On Sept. 27, 2016, New Scientist, a weekly international magazine, reported that a team of American scientists had produced the first three-parent baby through genetic engineering and in vitro fertilization. The scientists did their work in Mexico because the revolutionary technology using the DNA of three individuals to produce the baby is not legal in the United States. Some are greeting this latest break-through with great enthusiasm as a way to stop certain diseases. Others are expressing their grave concerns about the morality of such technology.
For almost 40 years, our secular culture has wholeheartedly embraced and promoted in vitro fertilization as an ethical reproductive technology. Good-intentioned individuals desiring to have children have not always taken the time to assess critically this method of manufacturing babies. As for any human act, discernment is required to determine whether it is moral or not. Before acting, the judgment must be made whether in vitro fertilization is in accord with God's creative design or not.
There are many blessings in marriage. Each family is a sanctuary of life where God entrusts a child to the care of a mother and father. "Children are a gift from the Lord, the fruit of the womb, a reward" (Ps 127:3). As the Second Vatican Council teaches, "Children are the supreme gift of marriage and contribute very substantially to the welfare of their parents" (Gaudium et Spes, 50).
Sadly, in the United States, one out of every six married couples must deal with infertility. In 30 percent of all cases, male infertility is a factor. In 6 percent of all cases, the woman has difficulty in conceiving a child. The desire of these couples to cooperate with God in bringing a child into the world is noble and praiseworthy. So also is the desire to overcome the obstacles preventing the conception and birth of a child.